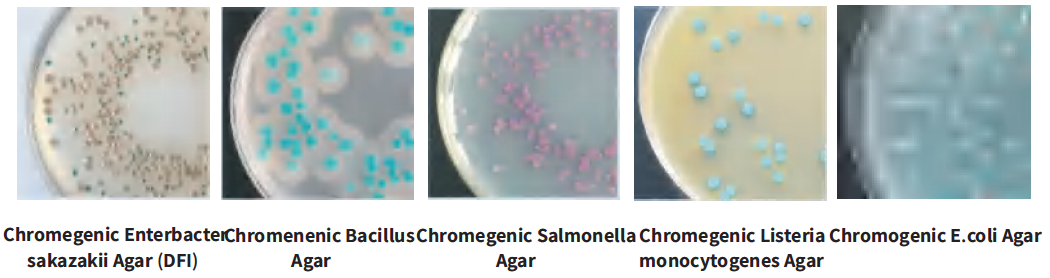

Jenis Media Tersedia:
|
Kode |
Nama Produk |
Spesifikasi |
Kegunaan |
|
CRM001 |
Chromogenic Coliform Agar |
250g, 500g |
Deteksi cepat Coliform |
|
CRM002 |
Chromogenic E.coli Agar |
250g, 500g |
Deteksi cepat E.coli |
|
CRM003 |
Chromogenic Coliform E.coli (ECC) Agar |
250g, 500g |
Deteksi cepat Coliform dan E.coli |
|
CRM004 |
Chromegenic Salmonella Agar |
250g, 500g |
Deteksi dan Isolasi Salmonella spp |
|
CRM005 |
Chromenenic Bacillus Agar (with supplement) |
250g, 500g |
Deteksi dan diferensiasi Bacillus cereus group |
|
CRM006 |
Chromogenic Enterbacter sakazakii Agar |
250g, 500g |
Deteksi E.sakazakii |
|
CRM007 |
Chromogenic E coli O157 Agar (with supplement) |
250g, 500g |
Isolasi selektif dan diferensiasi E.coli O157 |
|
CRM008 |
Chromogenic Vibrio Agar |
250g, 500g |
Isolasi dan deteksi Vibrio khususnya Vibrio parahaemolyticuscus |
|
CRM009 |
Chromogenic Vibrio Cholerae Agar |
250g, 500g |
Isolasi dan deteksi Vibrio cholerae |
|
CRM010 |
Chromogenic Candida Agar |
250g, 500g |
Isolasi dan diferensiasi Candida |
|
CRM011 |
Chromogenic Shigella Agar |
250g, 500g |
Isolasi dan diferensiasi Shigella |
|
CRM012 |
Chromogenic Staphylococcus aureus Agar |
250g, 500g |
Isolasi dan diferensiasi Staphylococcus aureus |
|
CRM013 |
Chromegenic Listeria monocytogenes Agar (with supplement) |
250g, 500g |
Isolasi dan diferensiasi Listeria monocytogenes |
|
CRM014 |
Chromegenic Listeria Agar (with supplement) |
250g, 500g |
Isolasi dan diferensiasi Listeria |